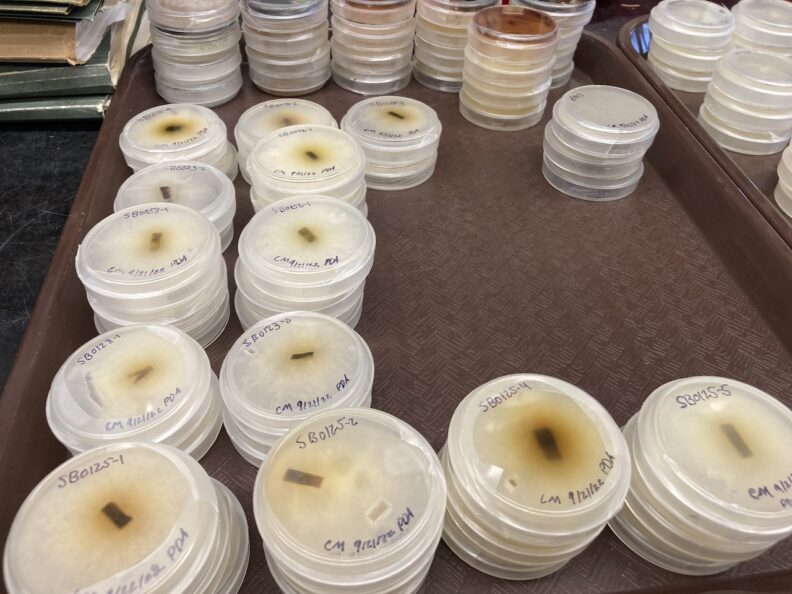
C corticale isolates

WSU Urban Forest Health Lab
Welcome
Welcome to the website for the WSU Urban Forest Health Lab. This WSU program and website were established from the generous support from the Albert Victor Ravenholt Fund. Visit the About page to learn more about the program or contact us to start a conversation.

2025 Annual Report (PDF – 36.2MB)
- More than 80% of people in the United States live in cities and rely on healthy, functioning urban forests.
- Urban trees provide critical services for keeping communities healthy, such as mitigating the impacts of heat waves, but these benefits are not equally distributed and more research is needed to improve the functioning of urban forests equitably.
- In the Pacific Northwest, there is enormous need—and opportunity—to equitably increase the resilience of communities by advancing knowledge and stewardship for growing healthy and vibrant urban forests.
Learn more about our active research projects below
- Western Sword Fern Dieback
- Redcedar health and urban Heat Study
- Climate Adaption
- Tacoma Schools, Urban Heat, and Trees (Story Map)
- Sentinel Tree Project
- Sooty Bark Disease Vulnerability
Check out our other projects here

Learn more about our community projects below
- Tacoma Volunteer Tree Inventory
- Western Redcedar Parks Project
- Community College Partner Program in Urban Tree Equity
- Redcedar Intensive Care Collaborative
- Community Science
Click here for our other community engagement opportunities





Contact us to get started with an student internship or research position.






Recorded Webinars
Recordings of the 2023 and 2024 Workshops and Webinar Series are available online.
Upcoming Events

News
First Detectors Trainings
Join us either June 11th or July 9th for an in-depth online trainings discussing signs and symptoms of invasive species and how to report in your region! Event Page: https://treehealth.wsu.edu/first-detectors/
Community scientist update and networking event
Register to participate at https://wsu.zoom.us/meeting/register/dWxYXUzvQqmeXNs2_VH85Q

